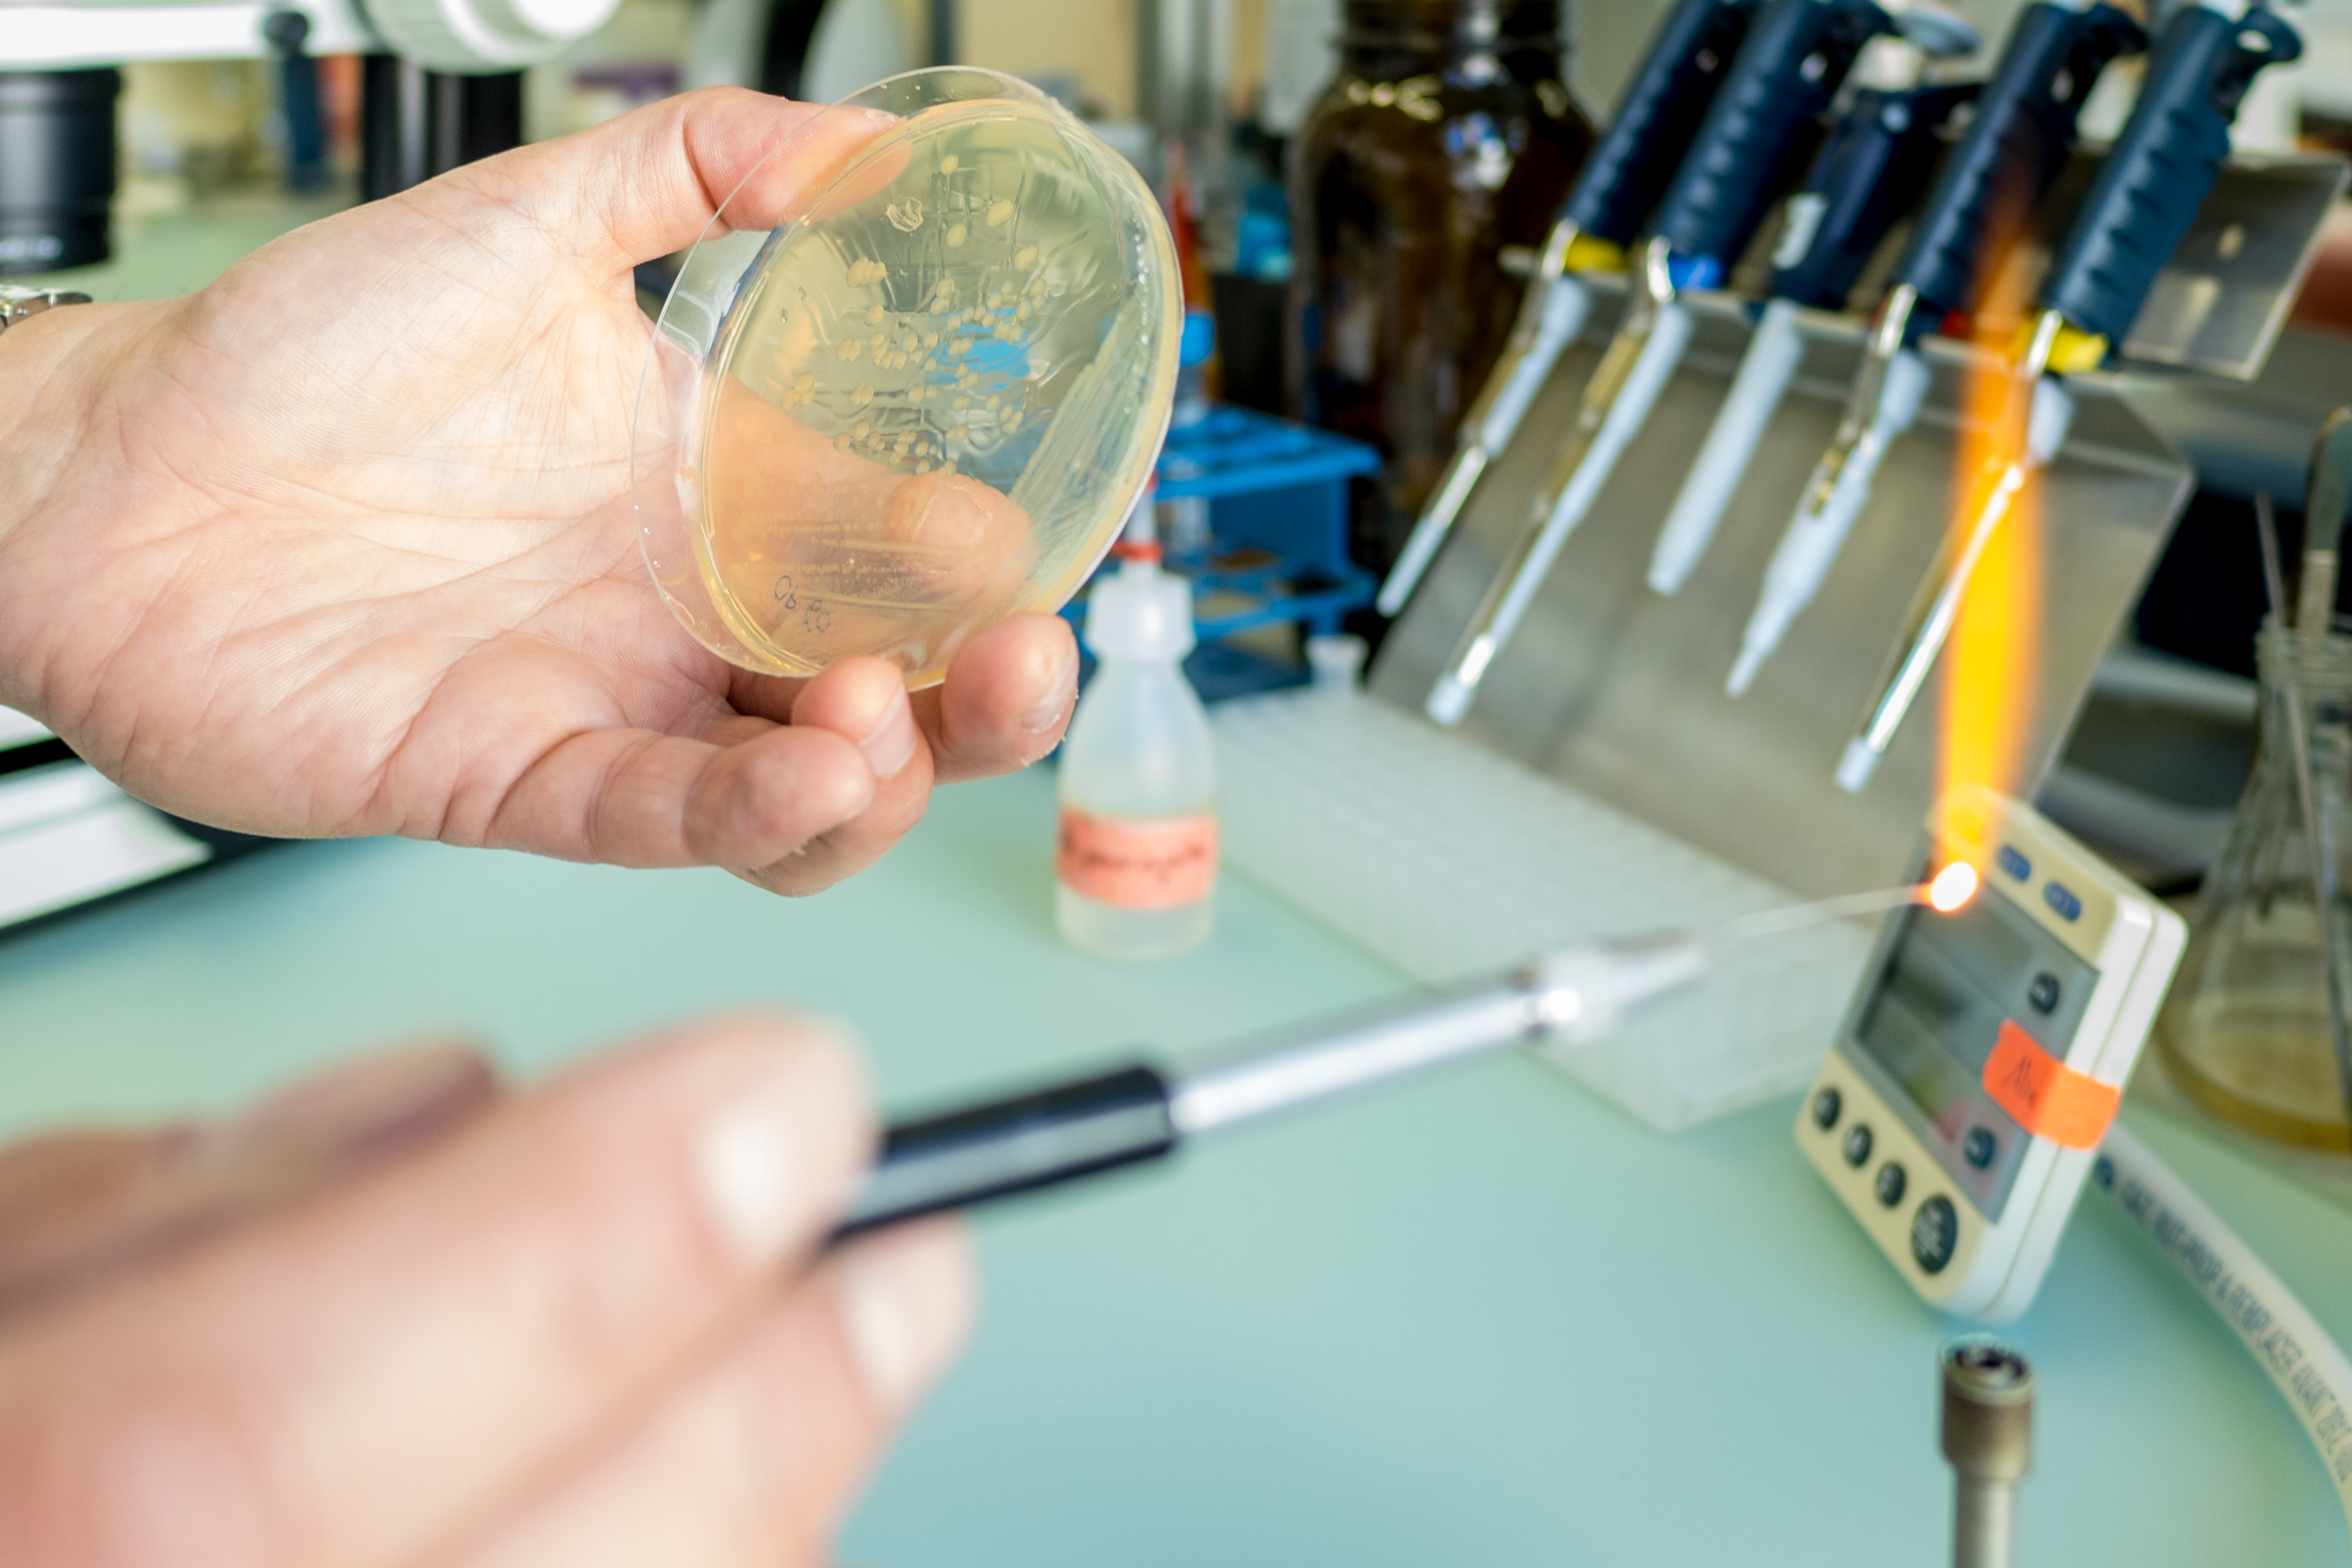

Information for prospective students
Notre programme d'études de base en 3 ans mène à un diplôme de « Bachelor of Sciences ». Vous avez ensuite la possibilité de poursuivre avec un « Master of Sciences » dans lequel vous choisirez une spécialité dans un domaine donné de la biologie. Les études sont bilingues (français et allemand). Ce bilinguisme sera mentionné sur votre diplôme et constituera un atout sur le marché du travail. Cependant, comme nous sommes dans le domaine des sciences, beaucoup de nos cours sont dispensés en anglais. Notre programme d'études est intégré au système européen de « Bologne », qui ouvre la voie à des opportunités de travail ou d'études à l'étranger. Industrie biomédicale, laboratoires, enseignement, agences gouvernementales et ONG, bureaux d'évaluation d'impact (impact assessement offices), institutions de santé publique, compagnies d'assurance et de statistiques, journalisme scientifique : voici quelques-unes des opportunités de carrière qui s'offrent aux biologistes. Vous pouvez également poursuivre vos études avec un doctorat et faire de la recherche votre profession.